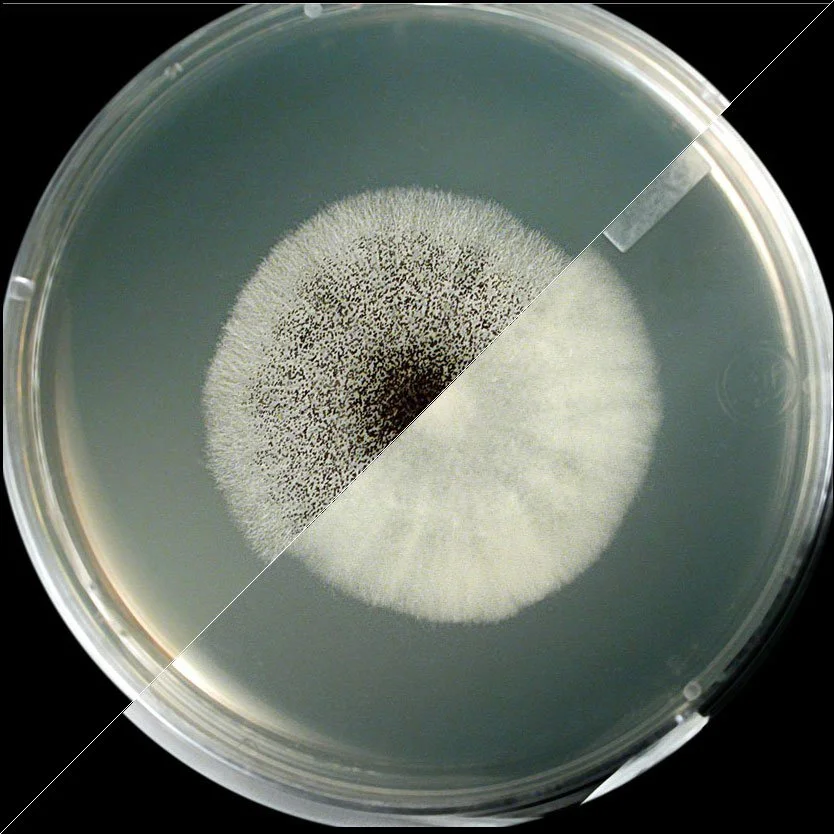

Innovating the future of Healing with Science.

Our Science and Research
Over the eight years the team has dedicated significant effort to develop clinical formulas and specialized protocols to offer comprehensive and personalized treatments as every client has unique needs, tolerance levels, and experiences.
Our team includes mycologists, researchers, biologists, biochemists, doctors, neuroscientists, psychotherapists, psychiatrists, and healers working together to find new paths that provide alternatives for comprehensive body-mind-spirit health.
Together they conduct scientific investigations into ancestral medicines and their impact on consciousness and human health using state-of-the-art technology.

We conduct research using a sophisticated analytical method to identify and quantify mycology, related tryptamines, and beta-carbolines, including Norbaeocystin, Aeruginascin, Baeocystin, Norpsilocin, Harmalol, Norharmane, Harmane, and Harmine, in mushroom species and formulations. Our process employs high-performance liquid chromatography (HPLC) with UV-Vis detection, ensuring precision and reliability in every analysis.
This advanced methodology enables us to map the molecular profile of our mushroom species and formulations, providing deep insights into their expected effects on key neurotransmitters, particularly serotonin subreceptors.
The unique “molecular fingerprint” of each mushroom and formula allows us to design our products and protocols with unparalleled precision, ensuring consistency and efficacy.
Precision in Formulation Design


MULTIDISCIPLINARY TEAM OF PROFESSIONALS AND SCIENTISTS
We are a team with diverse perspectives which allows us to build sound scientific knowledge,a highly efficient production process and effective management capabilities.




We are currently in the middle of a study program with European Universities to deepen the understanding of how the different chemical compounds of the mushrooms bind to specific neurotransmitters, which allows us to develop effective and precise protocols.
We have successfully helped more than +1,000 people wean off of antidepressants with a 96% success rate.
81% of people feel very satisfied with the program.
90% reported to be able to change habits and patterns.
81% feel less stress.
Dream it
81% of people feel very satisfied with the program. 90% reported to be able to change habits and patterns. 81% feel less stress. Dream it
77% have overcome depression
79% report less anxiety
78% are more connected with their emotions
77% have overcome depression 79% report less anxiety 78% are more connected with their emotions
85% have improved their self-observation capacity
78% have improved their sleep quality
93% improved their cognitive capacities
85% have improved their self-observation capacity 78% have improved their sleep quality 93% improved their cognitive capacities

We research the complete fungi natural spectrum.
While most studies and clinics around the world are using synthetic psilocybin, we are using the natural fungi compound spectrum because it has synergistic health benefits.
WE FOCUS ON INTEGRATION
We know that no substance by itself can completely alleviate the root causes of the current global mental health crisis.
We have developed a therapeutic coaching approach to guide people through the process of adapting and incorporating the benefits of mycology from certain fungi into their everyday activities.



